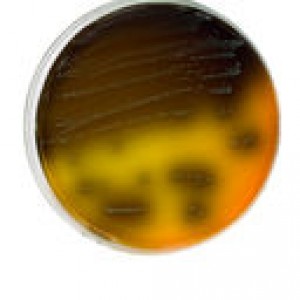

News
Blue Bell working with FDA on remedial actions
16 Jun 2015Following the across-the-board product recall it was forced to undertake as a result of a listeria outbreak that caused three deaths, Blue Bell Creameries has provided the U.S. Food and Drug Administration (FDA) a detailed list of corrective actions that are underway in response to the agency’s inspection reports of Blue Bell’s Brenham, Texas, Broken […]
Following the across-the-board product recall it was forced to undertake as a result of a listeria outbreak that caused three deaths, Blue Bell Creameries has provided the U.S. Food and Drug Administration (FDA) a detailed list of corrective actions that are underway in response to the agency’s inspection reports of Blue Bell’s Brenham, Texas, Broken Arrow, Oklahoma, and Sylacauga, Alabama, ice cream production facilities.
Following the across-the-board product recall it was forced to undertake as a result of a listeria outbreak that caused three deaths, Blue Bell Creameries has provided the U.S. Food and Drug Administration (FDA) a detailed list of corrective actions that are underway in response to the agency’s inspection reports of Blue Bell’s Brenham, Texas, Broken Arrow, Oklahoma, and Sylacauga, Alabama, ice cream production facilities.
Blue Bell says it is taking the FDA observations very seriously, according to CEO and President Paul Kruse, noting that the company’s highest priority is to produce safe, wholesome, high-quality products for consumers to enjoy.
The company is currently in the process of comprehensively reviewing all aspects of operations at the three facilities. Because listeria is ubiquitous in the environment, the company has adopted a broadly focused remediation plan aimed at confronting any possible sources of contamination.
This process has, said the company, led Blue Bell to “reassess everything” about its operations and identify a number of enhancements that will be made, including updated environmental and product testing procedures.
The company is focusing on ensuring that all aspects of its facilities and production lines are clean and sanitary, and result in a safe product, Kruse said.
Blue Bell says it is taking a consistent approach at all of its facilities, and will be using the same standard operating procedures, testing programs, supplier verification procedures, and overall philosophy at the three plants.
“We hope our efforts demonstrate the seriousness with which we are taking this situation, as well as our commitment to making sure we get this right,” Kruse said. “We are committed to seeing this plan through and to working with the FDA each step of the way. Once Blue Bell, the FDA and the applicable state regulators agree we are ready to reintroduce products into commerce, we plan to resume production with a phased-in selection of flavors and sizes, expanding only after our revised programs have demonstrated they are capable of ensuring product safety.”
